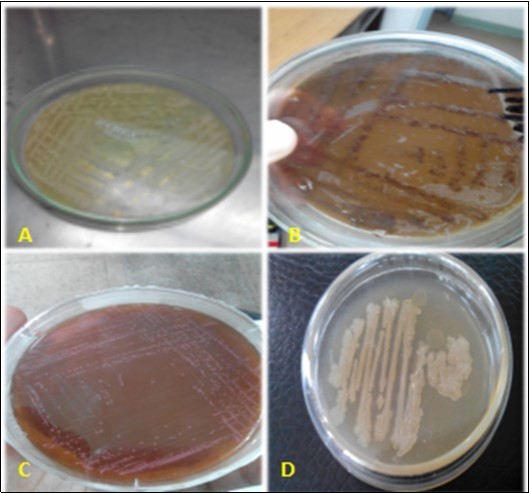

Morpho-biochemical Identification and Antimicrobial Susceptibility Testing of Bacterial Isolates from Chicken Eggs in District Faisalabad
Abstract
Microorganisms are the main cause of food-borne illness in humans that may occur by consuming unhygienic products from poultry and other sources. With the passage of time bacterial resistance to antibiotics is ever-increasing which necessitates development of new antibiotics. One of the most obvious reasons of antimicrobial resistance in human-beings is the consumption of contaminated food with microbes. The aim of present study is to isolate, identify and characterize the food-borne pathogens from chicken eggs. For this purpose, a total of 240 egg samples were collected from eight different towns of Faisalabad. Samples were collected from egg surface, yolk, albumin and egg tray. Isolation, identification and characterization of commonly occurring egg borne pathogens including E. coli, Salmonella spp., Bacillus subtilis, Staphylococcus aureus were carried out by different cultural, morphological and biochemical tests. Antibiotic resistance pattern of recovered bacterial pathogens was determined by disk diffusion method (Kirby-Bauer). Zone of inhibition was measured through vernier calliper. The results revealed a high prevalence of Salmonella entitidis with 40.83% following Staphylococcus aureus with 22.08%, Escherichia coli with 17.92% and Bacillus subtilis in a lower ratio with 2.5%. The antibiotic sensitivity test showed different resistance patterns of the isolated microbes. For this purpose, five different drugs were used that included cefotaxime, tetracycline, gentamicin, levofloxacin and penicillin. Bacillus subtilis was highly resistant to penicillin and cefotaxime. Whereas, E. coli showed resistance to three antibiotics that were tetracycline, cefotaxime and penicillin. The only drug to which Staphylococcus aureus showed resistance was cefotaxime. Salmonella was resistant to tetracycline and gentamicin. The study concluded that chicken egg is contaminated with a number of bacteria that could be pathogenic or not. So, there is need of proper attention to cope up with possible future egg-borne illnesses.
Author Contributions
Academic Editor: Mujeeb Nasar, Huazhong Agricultural University, Wuhan China
Checked for plagiarism: Yes
Review by: Single-blind
Copyright © 2018 Neelma Ashraf, et al.
 This is an open-access article distributed under the terms of the Creative Commons Attribution License, which permits unrestricted use, distribution, and reproduction in any medium, provided the original author and source are credited.
This is an open-access article distributed under the terms of the Creative Commons Attribution License, which permits unrestricted use, distribution, and reproduction in any medium, provided the original author and source are credited.
Competing interests
The authors have declared that no competing interests exist.
Citation:
Introduction:
Poultry is one of the most important sectors in agriculture industry of Pakistan 1 contributing about 11.9% in gross domestic product (GDP) of Pakistan and about 55.4% in year 2016-17 in the agriculture sector as a rapidly growing sector 2. Poultry industry is a big source of human food in the form of meat and eggs 3.
Egg is considered as a sole source of essential nutrients and it carries majority of proteins vital to human health. In spite of essential part in diet, different bacteria are found in eggs as a contamination or in-ovo transfer such as Salmonella species, Listeria monocytogens, Camphylobacterjejuni, Staphylococcus aureus and E. coli4. The majority of the marketable eggs are sterile and the yolk is delimited by albumen which has high water content, flexibility and shock absorbing ability. The outer surface of the shell is cuticle which consists of a mucous coating deposited just before laying. This cuticle layer aids to protect the internal substances of the egg from bacterial access through the shell 5.
Microorganisms are the major cause of food borne diseases in human that occur by consuming unhealthy products from poultry and other sources. Among all microbes, bacteria are the most common organism to cause illness 6. Campylobacter is most commonly found bacteria in poultry products like eggs and meat. It is the main cause of gastroenteritis in humans. It is horizontally transmitted via infected livestock and free-living animals 7. Microbes depreciate the quality of eggs, impairs growth and decreases the performance of birds 8. Egg containing Salmonella can cause food poisoning although it appears normal. In this way, egg is used as a vector by these microbes in causing illness to humans 9.
Immunity is the capacity of the body to resist the invading organisms. Immunity works by the immunoglobulins and white blood cells. Immunity of chicks may be modified by active or passive immunity 10. In poultry industries, different kind of vaccines and antibiotics are being given to animals to increase growth and food production. These drugs may reside in their body for a prolonged time. Thus, the present study was designed to investigate chicken egg samples obtained from different areas of district Faisalabad to isolate and identify the bacteria through morphological and biochemical tests and then through antibiotic sensitivity evaluation to sort out which bacterial species are resistant to commonly used drugs including; penicillin, cefotaxime, tetracycline, gentamicin and levofloxacin in poultry sector.
Material and Method:
Raw Sample Collection and Categorization:
A total of 256 samples were collected from eight different towns of Faisalabad namely: D-Ground, Motorway city, Madina town, Batala colony, Millat town, Iqbal town, Gulberg colony and Ghulam Muhammadabad. The samples were collected by using simple random sampling technique. Samples were divided into four categories as: Egg tray, Egg shell, Egg yolk and albumin. Total 32 samples (8 per category) were collected from each selected town of Faisalabad (Figure 1).
Figure 1.Eight different towns of district Faisalabad. Red lines indicate the tract of 8 towns for sample collection.
Sample Storage:
The samples were then carried to laboratory for the Institute of Microbiology, University of Agriculture Faisalabad, under sterile conditions and were stored at 4oC for further analysis.
Microbial Isolation and Culturing from Sample:
A wet sterile cotton swab was used for isolation purpose. It was swabbed on egg storing tray surface and then it was transmitted to peptone water. It was incubated at 37°C for 18 hours. A sterile cotton swab, soaked in sterilized normal saline was swabbed on egg surface and then it was transmitted to peptone water and incubated at 37°C for 18 hours. Samples of egg yolks and egg albumins were examined separately as 5 ml of each sample was mixed with 5 ml of normal saline solution. Afterwards, the solution was transferred to peptone water and then it was incubated at 37°C for 18 hours 5, 11.
Culture Characters and Microbial Identification:
It was identified by growing the microorganisms in different general-purpose media, selective media and differential media e.g. Nutrient agar, MacConkey agar, Staph 110 agar, Eosin methylene blue agar, Salmonella shigella agar etc. 5.
Purification of Bacterial Growth:
After counting, colonies of different appearance on all agars and in all sample were separately streaked on respective agars for obtaining pure colonies indicative of individual bacterial genus and species. Then incubation is done for 24 hours at 37ºC.
Streak Plate Method for Bacterial Growth:
Streaking is a technique used to isolate a pure strain from a single species of microorganism, often bacteria 5.
Morphological Identification
Gram staining, spore staining, capsular staining and flagella staining techniques were used for morphological identification of microorganisms.
Biochemical Identification
Various biochemical tests were used for identification of microorganisms including: Indole test, Methyl red test, Voges- Proskauer test, Citrate utilization test, Catalase test, Starch Hydrolysis test, Triple Sugar Iron agar test, Urease test, Coagulase test, Sugar Fermentation test e.g., Glucose, Mannitol, Fructose etc. 12, 13.
Antibiotic Sensitivity Testing:
Kirby-Bauer antibiotic testing (KB testing or disk diffusion antibiotic sensitivity testing) was used for antibiotic-impregnated wafers to test whether bacteria are affected by antibiotics on the basis of visibility and size of zone of inhibition 12, 14.
Statistical Analysis
Data was collected, tabulated and analyzed statistically by Analysis of variance (ANOVA) using SPSS17.0.
Results:
Bacteria from nutrient agar (general purpose media) were streaked on MacConkey’s agar, Eosin methylene blue agar, Staphylococcus 110 agar and Salmonella-Shigella agar as shown in Figure 2. Then, biochemical tests were applied for further confirmation of identification. The results are displayed in Table 1. Whereas, glucose, lactose and sucrose fermentation abilities of these bacteria were shown in Figure 3. The result of triple sugar iron fermentation to differentiate between fermenting and non-fermenting bacteria with the ability of acid production from fermentation is displayed in Table 2. Resistance and sensitivity profile of various bacterial isolates against different drugs has been shown in Table 3. Zone of inhibition of various bacterial isolates using different antibiotic disks have been shown in Figure 4.
Figure 2.Streak plating of bacterial on their respective differential medium. A= Staphylococcus aureus on Staph 110 agar, B= Salmonella spp. on Salmonella-Shigella agar, C= E. coli on MacConkey’s agarand D= Bacillus subtilis on Eosin methylene blue agar
| Bacterial isolates | Tests | Results (+/-) |
|---|---|---|
| Salmonella enteritidis(G –ve) | Indole test | -ve |
| VP test | -ve | |
| Methyl red | +ve | |
| Citrate test | +ve | |
| Urease test | -ve | |
| Escherichia coli(G –ve) | Indole test | +ve |
| Methyl red | +ve | |
| VP test | -ve | |
| Citrate test | -ve | |
| Catalase test | +ve | |
| Staphylococcus aureus(G +ve) | Catalase test | +ve |
| Coagulase test | +ve | |
| Bacillus subtilis(G +ve) | VP test | +ve |
| Citrate test | +ve | |
| Starch hydrolysis test | +ve (clearing around bacteria) |
Figure 3.TSI Slants showing different butt and slant color patterns. Glucose, sucrose and lactose fermentation ability of different bacteria help to identify their genera on the basis of patterns of colour changes in butt and slant. This test also help to identify gas producers and H2S producing bacteria as well.
| Sr. No. | Bacterial Isolates | Glucose Fermentation | Sucrose Fermentation | Lactose Fermentation | H2S Production | Gas Production |
| 1 | E.coli | + | + | + | - | + |
| 2 | Staphylococcus aureus | |||||
| 3 | Salmonella | + | - | - | + | + |
| 4 | Bacillus subtilis |
| Bacteria | Drugs | ||||
| Penicillin | Tetracycline | Cefotaxime | Gentamicin | Levofloxacin | |
| Bacillus subtilis | - | + | - | + | + |
| Staphylococcus aureus | + | + | - | + | + |
| Escherchia coli | - | - | - | + | + |
| Salmonella entritidis | - | + | - | + | + |
Figure 4.Zone of inhibition of various bacterial isolates using different antibiotic disks. Whereas P= Penicillin, C= Cefotaxime, G= Gentamicin, L= Levofloxacin and T=Tetracyclin
Biochemical Tests (IMViC tests):
Discussion:
Poultry is known to be the oldest on earth. It is known for over 150 million years. Poultry species include ducks, geese, turkeys, pheasants, pigeons, peafowl, guinea fowl and chickens. Poultry is important in providing food and fiber to humans in the form of eggs and meat. Among all poultry species chicken is the most commonly used specie for human food consumption. The commercial chicken is the largest industry that provides with eggs and meat 15. Globally, the production of poultry products like eggs and meat is rapidly increasing. This reflects that the consumption of these products has also been increased. According to different researches an overall consumption of poultry products from 1995 to 2005 has increased globally with the ratio of 53% for chicken meat, 13% for turkey meat, 67% for duck meat, 53% for goose meat, 39% for chicken eggs and 27% for other eggs. Therefore, it is important to know that what types of contaminants may be present in these products and what risks they can cause to human health 16. Microbes depreciate the quality of eggs, impairs growth and decreases the performance of birds 8.
Antibiotic resistance is a natural phenomenon. Data regarding the prevalence of antibiotic resistance and the types of ESBLs produced by E. coli are available for certain regions of China and from many other countries 17, 18. In a study conducted in China, ninety-seven percent of the E. coli isolates were resistant to at least three different classes of antibiotics (MDR), whereas 18% were resistant to all antimicrobials tested 18, 19. Isolation, identification and characterization of commonly occurring egg borne pathogens including E. coli, Salmonella entritidis, Bacillus subtilis, Staphylococcus aureus was carried out by different cultural, morphological and biochemical tests. For culturing these microbes different culture media were used that include: Nutrient agar, Salmonella-shigella agar, MacConkey agar, Eosin-methylene blue agar. Antibiotic resistance pattern of recovered bacterial pathogens were determined by disk diffusion method (Kirby-Bauer). Zone of inhibition was measured through vernier calliper. Data was analyzed by Analysis of variance. The results revealed a high prevalence of Salmonella entitidis with 40.83% following Staphylococcus aureus with 22.08%, Escherichia coli with 17.92% and Bacillus subtilis in a lower ratio with 2.5%. This showed that Bacillus subtilis is present in a very low amount in chicken egg. The antibiotic sensitivity test showed different resistance patterns of the isolated microbes. Bacillus subtilis was highly resistant to penicillin and cefotaxime while it sensitivity for gentamicin, tetracycline and levofloxacin. E. coli was sensitive to gentamicine and levofloxacine while it showed resistance to other three antibiotics that were tetracycline, cefotaxime and penicillin. Staphylococcus aureus was sensitive to different drugs naming penicillin, gentamicin, tetracycline and levofloxacine. The only drug to which Staphylococcus aureus showed resistance was cefotaxime. Salmonella was resistant to tetracycline and gentamicin. Thus, proper attention should be paid to cope up with possible future egg-borne illnesses as in present study chicken eggs have been found contaminated with different pathogenic or non-pathogenic bacterias.
References
- 1.Jamali B, H J Soomro, A H Halepoto, Hashmi A, F M Shaikh. (2011) Problems faced by the poultry industry in Pakistan. , Aust J Busin Managem Resear 1, 96-100.
- 3.Ashraf N, Rashid A, Naz U, M, Khaliq S et al. (2018) Detection of antibiotics residues in protein containing diets (meat and eggs) of human through different methods. , JUMDC 9, 1-11.
- 4.H S Ghasemian, Jalali M, Ahad H, Tahmineh N, Ali S et al. (2011) The prevalence of bacterial contamination of table eggs from retails markets by Salmonella spp., Listeria monocytogenes, Campylobacter jejuni and Escherichia coli in Shahrekord, Iran. , Jundi J Microbio 4, 249-253.
- 5.Abdelqadera A, A R, Das G. (2013) Effects of dietary Bacillus subtilis and inulin supplementation on performance, eggshell quality, intestinal morphology and microflora composition of laying hens in the late phase of production. , Anim Feed Sci Tech 179, 103-111.
- 6.Van T T, Chin J, Chapman T, Tran L T, Coloe P J. (2008) Safety of raw meat and shellfish in Vietnam, An analysis of Escherichia coli isolations for antibiotic resistance and virulence genes. , Int J Food Microbio 124, 217-223.
- 7.Hermans D, K V Deun, Messen W, Martel A, F V Immerseel et al. (2011) Campylobacter control in poultry by current intervention measures ineffective: Urgent need for intensified fundamental research. , Vet Microbio 152, 219-228.
- 8.Ashraf A, M, Rafiqe A, Aslam B, Galani S et al. (2017) In vivo antiviral potential of Glycyrrhiza glabra extract against Newcastle disease virus. , Pak J Pharm Sci 30, 567-572.
- 9.Tellez G, Pixley C, R E Wolfendenb, S L Laytona, B M Hargis. (2012) Probiotics/direct Fed Microbials for Salmonella Control in Poultry. , Food Research Int 45, 628-633.
- 10.Akram M, Shah SMA, Sarwar M A, Ashraf N, Aslam B et al. (2017) Role of immunity and immunoglobulins in different ailments; a comprehensive review. , Pak J Med Biol Sci 1, 52-58.
- 11.Shahzad A, Mehmood M S, Hussain I, Siddique F, R Z Abbas. (2012) Prevalence of Salmonella species in hen eggs and egg storing-trays collected from poultry farms and marketing outlets of Faisalabad,Pakistan. , Pak J Agri Sci 49, 565-568.
- 12.Ashraf N, Hussain I, Siddique F. (2015) . Microbial Burden and Drug Residual Analysis in Raw Meat Samples from Different Towns of Faisalabad, Pakistan. Scholar’s Adv Anim Vet Res 2, 228-237.
- 13.R M Saliva, M R Toledo, L R Trabulsi. (1980) Biochemical and cultural characterstics of invasive Escherichia coli. , J Clin Micro 11, 441-444.
- 14.Jabbar A, S U Rehman. (2013) Microbiological evaluation of antibiotic residues in meat, milk and eggs. , J Micro Biotech Food Sci 2, 2349-2354.
- 15.Birol E, Asare-Marfo D, Ayele G, Mensa-Bonsu A, Ndirangu L et al. (2010) . Investigating the Role of Poultry in Livelihoods and the Impact of Avian Flu on Livelihoods Outcomes in Africa. Int Food Poli Res Ins 1, 1-40.
- 17.M U Rehman, Zhang H, M K Iqbal, Nabi F, Huang S et al. (2017) Antibiotic Resistance of Escherichia coli in Free-Ranging Yaks (Bos grunniens) from Tibetan Plateau,China. Pak Vet. , J 37, 139-144.
